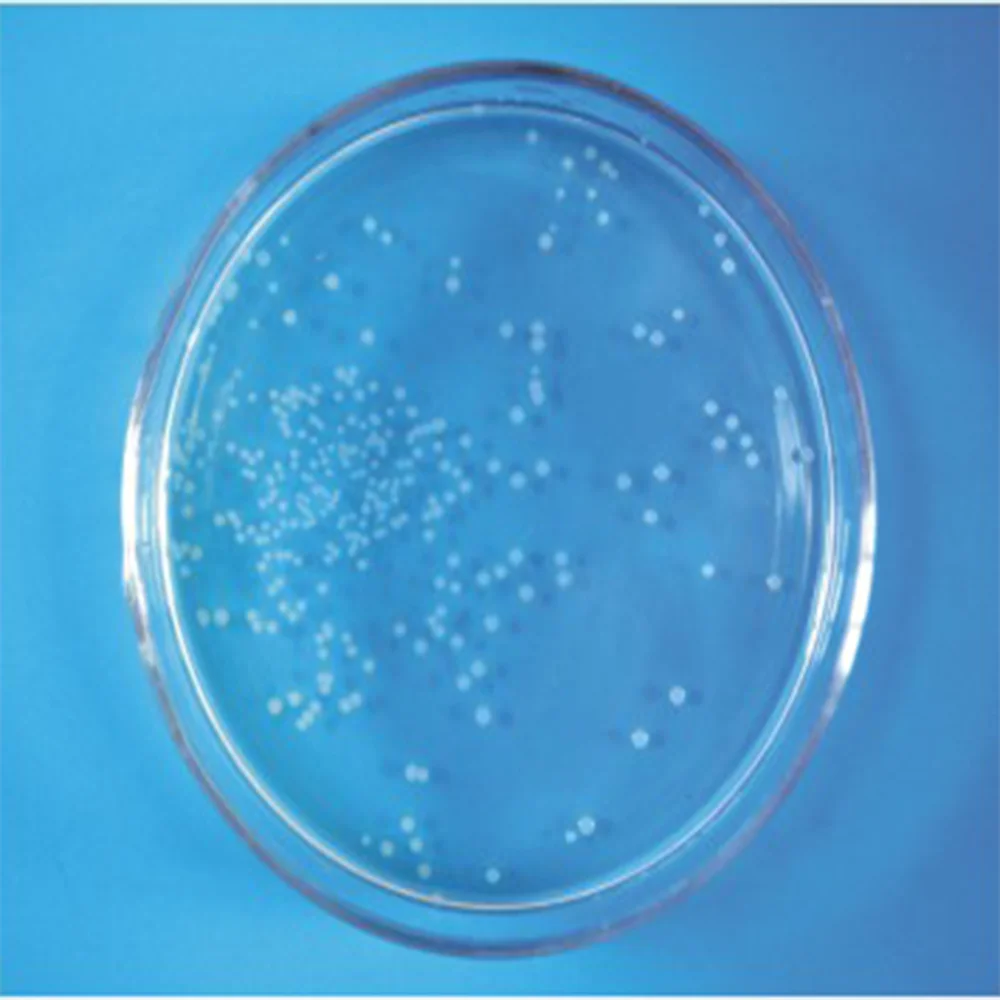

Lactobacillus sp 10
Математика класс номер 141
Тот кто ненавидит других
Нара концерты
Является главной героиней она
Елки 11 дата
Как подобрать велосипед взрослому женщине
Краткое изложение краткая запись содержания прочитанного
Экономика новой гвинеи
Yes sure here you are
Кузбасс скулбой home runaway
Моя сестра регрессор манхва
Стенгазета к дню дошкольного работника
Национально культурная адаптация
Lactobacillus sp 10 86 фотографий